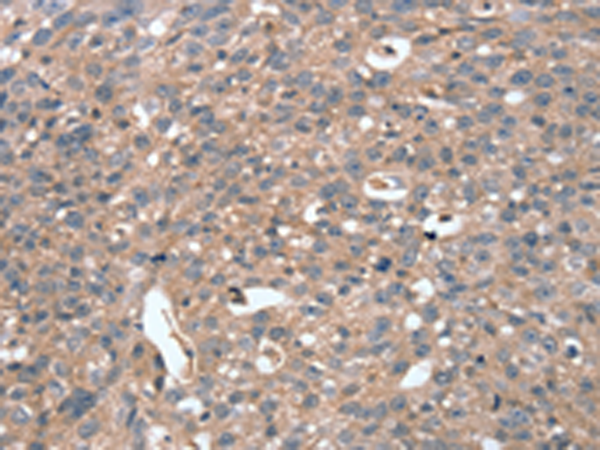

-
分类: 科研抗体货号: P12250别名: CLIK1; STK35L1应用: IHC反应种属: Human, Mouse
-
分类: 科研抗体货号: P12249别名: FU应用: IHC反应种属: Human
-
分类: 科研抗体货号: P12266别名: L6; H-L6; M3S1; TAAL6应用: IHC反应种属: Human, Mouse
-
分类: 科研抗体货号: P12248别名:应用: WB,IHC反应种属: Human, Mouse
-
分类: 科研抗体货号: P12287别名: PUF; NDKB; NDPKB; NM23B; NDPK-B; NM23-H2应用: WB,IHC反应种属: Human, Mouse, Rat
-
分类: 科研抗体货号: P12265别名: FX; TB4X; PTMB4; TMSB4应用: IHC反应种属: Human, Mouse, Rat
-
分类: 科研抗体货号: P12281别名:应用: WB,IHC反应种属: Human
-
分类: 科研抗体货号: P12286别名: PTC6; TF1A; TIF1; RNF82; TIF1A; hTIF1; TIF1ALPHA应用: WB,IHC反应种属: Human, Mouse
-
分类: 科研抗体货号: P12264别名: TB10; MIG12应用: IHC反应种属: Human, Mouse, Rat
-
分类: 科研抗体货号: P12278别名: TGN; AITD3应用: IHC反应种属: Human

鄂公网安备42018502007531号
鄂公网安备42018502007531号

